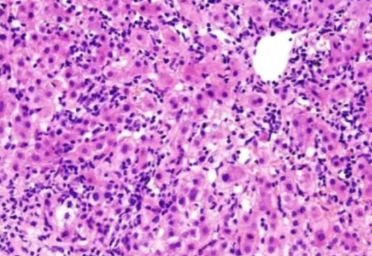
3.png

HE染色适用于生物医学、病理学科研与教学。在病理诊断中,HE染色是病理诊断上较广泛采用的常规染色方法,通过染色可以让组织在显微镜下显示得更清楚,有助于辅助做出正确的病理诊断。
今天给大家梳理了做HE染色中常常会遇到的问题以及对应的处理办法,此外还列举了实验中的注意事项!
一、染色不均

染色不均
原因:
1.切片厚度不一:切片有褶皱或裂痕致使过厚或过薄的部分在染色时吸收染液的程度不同,影响染液的渗透和分布,导致染色不均。
2.染色时间不足或过长。
3.脱蜡水化不充分。
4.试剂分布不均匀。
处理办法:
1.提高切片技术,确保切片厚度均匀,厚度一般在3~5微米,切片过程中避免产生刀痕和褶皱。
2.调整染色时间,严格按照标准时间进行染色。
3.脱蜡前确保玻片干透,严格按照标准时间把控二甲苯停留时间(二甲苯110min、二甲苯110min)。
4. 在染色过程中适当晃动切片。
二、细胞核染色过浅

细胞核染色过浅
原因:
1.苏木精染色时间不足:未能使细胞核充分摄取染料。
2.苏木精染液浓度过低:导致染色效果不佳。
3.分化过度:使细胞核中的染料被过多去除。
4.切片太厚:染液渗透不均匀,细胞核染色不充分。
处理办法:
1.适当延长苏木精染色时间,根据组织类型和切片厚度进行调整。
2.提高苏木精染液的浓度,确保其染色能力。
3.减少分化时间或降低分化液的浓度,避免过度分化。
4.重新切片,使切片厚度适中,以保证染液均匀渗透。
三、细胞核染色过深
细胞核染色过深
原因:
1.苏木精染色时间过长:导致细胞核摄取过多染料。
2.苏木精染液浓度过高:使染色强度过大。
3.分化不足:没有充分去除多余的染料。
处理办法:
1.缩短苏木精染色时间,根据实际情况进行微调。
2.降低苏木精染液的浓度。
3.延长分化时间或增加分化液的浓度,以去除细胞核中多余的染料。但要注意分化过度的问题,需在显微镜下观察控制分化程度。
四、细胞质染色过浅

细胞质染色过浅
原因:
1.伊红染色时间不足:导致细胞质摄取染料不够。
2.伊红染液浓度过低:染色能力较弱。
3.切片在伊红染液中浸泡不均匀:部分区域来充分接触染液。
处理办法:
1.适当延长伊红染色时间,同时在染色过程中轻轻晃动切片,确保染色均匀。
2.提高伊红染液的浓度,增强染色效果。
3.确保切片在伊红染液中充分漫泡,可适当调整切片的位置和角度。
五、切片出现模糊或有杂质

模糊 模糊、杂质伴随气泡
原因:
1.切片制作过程中出现不平整或者刀痕,切片组织因定不充分或脱水不完全导致。
2.染液放置时间过长、保存不当或被污染导致杂质产生。
3.冲洗时水流过大导致切片表面受损、冲洗不充分导致残留染液或杂志未被洗净。
4.封片胶中有杂质或封片过程中产生气泡。
处理办法:
1.提高切片技术,确保切片厚度均匀,切片过程中避免产生刀痕和。优化组织处理步骤,确保固定、脱水等环节操作规范。
2.定期更换和过滤试剂,并妥善保存。
3.调整水流大小和冲洗角度,避免损伤切片并充分冲洗。
4.过滤封片胶,去除杂质。封片时缓慢滴加封片胶,避免产生气泡。如有气泡,可用针尖轻轻刺破。
六、脱片

脱片
原因:
1.载玻片不干净:表面有油污、灰尘或杂质,影响切片的粘附。
2.组织处理不当:切片过厚,在后续处理过程中容易脱落。
3.粘附剂使用不当或失效:粘附剂的种类选择不合适;粘附剂涂抹不均匀或量不足。
4.烤片温度或时间不足:导致切片与载玻片粘附不牢因。
5.染色过程中的处理不当:脱蜡、水化、染色等步骤中操作过于剧烈,导致切片脱落。
处理办法:
1.确保切片厚度适中,一般为3~5微米。
2.对于易碎的组织,在切片时要更加小心,尽量切成薄而完整的切片。
3.选择合透的粘附剂,如多聚赖氨酸、APES等,并确保均匀涂抹适量的粘附剂。
4.烤片时温度控制在 60~65℃,时间1~2小时,使切片与载玻片充分粘附。
5.在染色过程中,动作要轻柔,避免剧烈晃动或搅拌切片。
七、注意事项
1. 切片制备:切片应薄而完整,厚度一般在3~5微米,切片过程中避免产生刀痕和。
2. 试剂使用:严格按照试剂说明书配制和使用试剂,定期检查试剂的有效性和浓度。
3. 脱蜡与水化:脱蜡要彻底,水化要充分,各步骤之间的梯度酒精过渡要平稳(95%乙醇、85%乙醇、75%乙醇依次漫润30s)。
4. 染色温度:染色过程中保持温度相对稳定,一般在室温下进行。
5. 冲洗:染色后的冲洗要充分,以去除多余的染色剂和杂质,但也要注意避免过度冲洗导致染色褪色。
6. 封片:封片时要避免产生气泡,封片胶的量要透中。
7. 显微镜观察:染色完成后及时在显微镜下观察,如有问题及时调整和重新染色。
8.实验记录:详细记录实验过程中的各项参数和操作步骤,以便于问题追溯和经验总结。
细胞实验外包 想了解更多请关注:http://www.do-gene.cn

